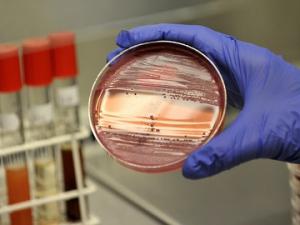
Фото с сайта prooren.ru

За год в Саратовской области на 8,7 процента увеличилось количество инфекционных и паразитарных заболеваний. В январе-июне 2018 года зарегистрировано 334 тысячи 259 подобных случаев, что на 25 тысяч 770 случаев больше, чем за тот же период прошлого года. Такие данные обнародовала сегодня, 24 июля, пресс-служба регионального управления Роспотребнадзора.
По информации ведомства, за первые 6 месяцев этого года жители губернии стали чаще болеть коклюшем, скарлатиной, ветряной оспой, инфекционным мононуклеозом, острыми вирусными респираторными инфекциями и гриппом.
В то же время зарегистрирован 12-процентный рост заболеваемости острыми кишечными инфекциями вирусной этиологии, в основном обусловленный вирусом Норволк (увеличение в 10,2 раза). Наибольшие показатели отмечены в Балаковском районе и Саратове, что специалисты регионального Роспотребнадзора связывают с активной лабораторной диагностикой ОКИ вирусной этиологии.
«За истекший период 2018 года зарегистрировано 146 случаев бешенства животных. По сравнению с аналогичным периодом 2017 года количество случаев бешенства среди животных выросло в 4,7 раза. <…> За медицинской помощью с повреждениями, нанесенными животными, обратились 3 тысячи 371 человек, что на 14,7 процента больше, чем в 2017 году. Высокий уровень обращаемости зарегистрирован в Питерском Дергачевском, Ивантеевском районах», - говорится в официальном пресс-релизе.
Вместе с тем, по информации управления, в январе-июне 2018 года снизилась заболеваемость сальмонеллезными инфекциями, острыми и хроническими вирусными гепатитами, туберкулезом, эпидемическим паротитом, геморрагической лихорадкой с почечным синдромом, сифилисом, педикулезом, чесоткой, энтеробиозом,описторхозом.











